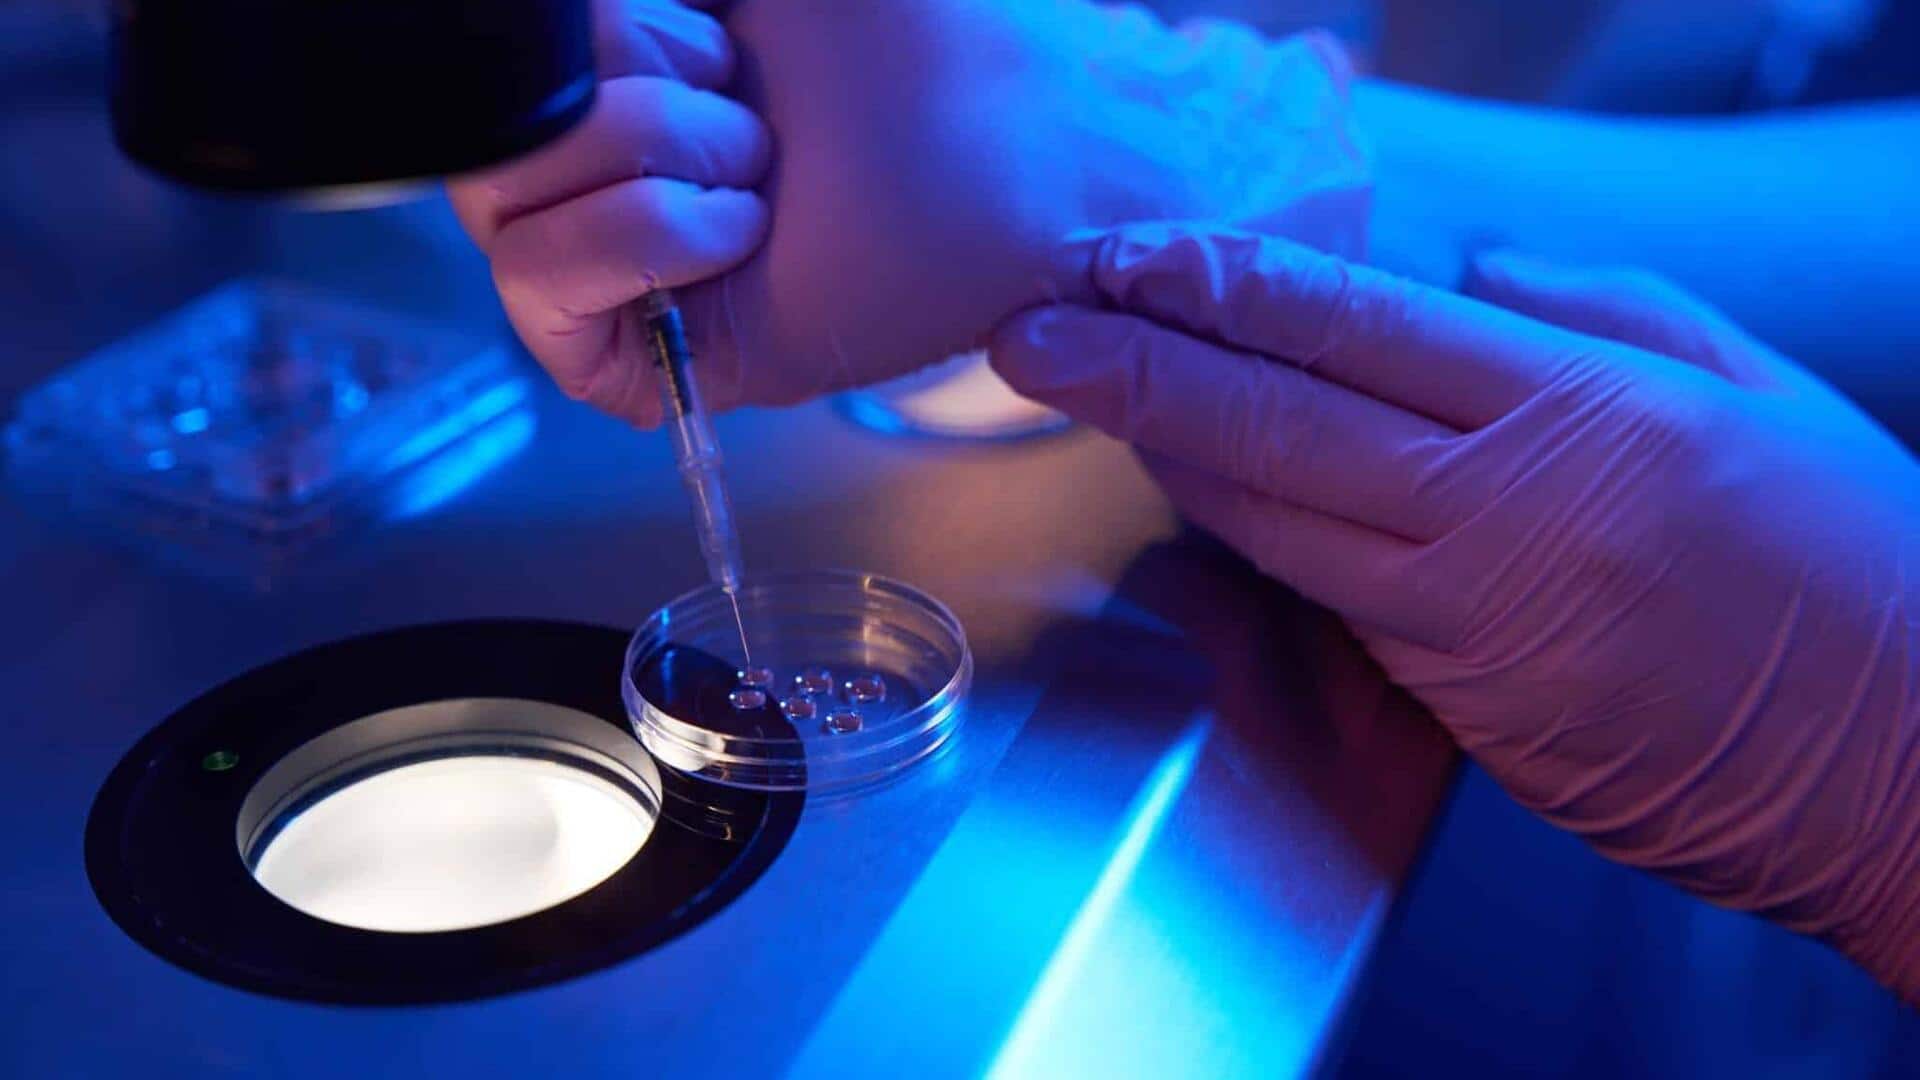
Scientists rejuvenate human eggs for first time, boosting IVF prospects

Scientists rejuvenate human eggs for first time, boosting IVF prospects
What's the story
In a groundbreaking development, scientists have successfully "rejuvenated" human eggs for the first time. The research could revolutionize in-vitro fertilization (IVF) success rates, especially among older women. The study shows that an age-related defect causing genetic errors in embryos can be reversed by supplementing eggs with a crucial protein. When fertility patients' donated eggs were microinjected with this protein, they were nearly half as likely to show the defect compared to untreated ones.
Potential impact
Protein microinjection could improve egg quality
If validated in larger trials, this method could greatly enhance egg quality, the leading cause of IVF failure and miscarriage in older women. "Overall we can nearly halve the number of eggs with [abnormal] chromosomes. That's a very prominent improvement," said Prof Melina Schuh from the Max Planck Institute for Multidisciplinary Sciences in Gottingen. The findings will be presented at the British Fertility Conference in Edinburgh and published as a preprint paper on Biorxiv.
Age factor
Egg quality decline linked to maternal age
The decline in egg quality is directly linked to maternal age, which is why IVF success rates plummet as women get older. For patients under 35, the average birthrate for each embryo transferred in IVF treatment was 35%. However, for women aged 43-44, this rate drops drastically to just 5%, according to recent UK figures. The average age of fertility patients starting treatment for the first time in the UK is now over 35.
Methodology
New technique targets vulnerability in eggs
The new technique targets a vulnerability in eggs associated with meiosis, a process where sex cells (eggs or sperm) discard half their genetic material to join together and form an embryo. In older eggs, chromosome pairs tend to loosen at their midpoint before fertilization. This results in embryos with too many or too few chromosomes. However, microinjections of Shugoshin 1 protein seem to reverse this problem by acting as a glue for the chromosome pairs.
Early results
Rejuvenation technique shows promise in early tests
In tests using eggs donated by patients at the Bourn Hall fertility clinic in Cambridge, the number showing the defect decreased from 53% in control eggs to 29% in treated ones. A similar trend was observed for women over 35 years of age (65% compared with 44%). However, this result wasn't statistically significant due to a small sample size of only nine treated eggs in this age range.
Next steps
Future trials and safety concerns
The team plans to conduct further research into safety of this approach, which could be a game-changer for women struggling with infertility. However, it won't extend fertility beyond menopause when the egg reserve runs out. Currently, there are no treatments involving microinjections into eggs apart from intra-cytoplasmic sperm injection (ICSI). The team is in talks with regulators about a clinical trial but an important question remains whether these improvements in egg quality would result in embryos with fewer genetic errors.